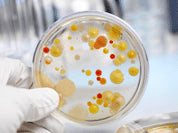
Digestive Alert – Thyroid, Celiac, and Candida

A study shows that digestive distress can trigger a chain of events that leads directly to thyroid damage. It has been observed that individuals with celiac disease (gluten intolerance) also have thyroid problems. Scientists tracked down the link by establishing that autoimmune antibodies against transglutaminase (a celiac problem) latch on to thyroid tissue and rev up thyroid autoantibodies (TPO - antithyroperoxidase antibodies), leading to thyroid tissue damage1.
This is the first time a clear chain of events has been specifically identified. This very important finding extends far beyond celiac, as transglutaminase is also formed from an overgrowth of candida. During candida overgrowth the candida induces inflammatory tissue damage along the lining of your digestive tract, like weeds spreading in a lawn and disturbing the structure of the lawn. The candida takes dead digestive tract cells and makes a hard goop, like a turtle shell over the outside of itself. It then attaches this shell to the walls of your digestive tract with little scab-like threads called transglutaminase, while it hides underneath the shell to escape your immune system. When gluten passes through the transglutaminase it causes a highly inflammatory reaction, which eventually generates celiac-like autoantibodies. This is true whether you have clear-cut celiac or not. In fact, candida can cause celiac by this mechanism.
In working with thousands of people who have candida over the years, it is clear that a high percentage of them have thyroid problems and elevated thyroid autoantibodies. This is a lesson for anyone; balance your digestive tract or run the risk of autoimmune-driven wear and tear to your thyroid gland. The precise mechanism is now understood. It also means that by clearing out a candida problem thyroid function will improve.
Digestive Alert – Thyroid, Celiac, and Candida
Byron J. Richards, Board Certified Clinical Nutritionist